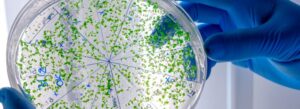
resistencia a los antimicrobianos

Semana Mundial de la Salud 2023: «Salud para todos»
La Semana Mundial de la Salud, organizada por la OMS anualmente, es un evento destacado en el ámbito de la salud. Este año el tema

La Semana Mundial de la Salud, organizada por la OMS anualmente, es un evento destacado en el ámbito de la salud. Este año el tema

El Día Mundial de la Esclerosis Múltiple se conmemora el 30 de Mayo de cada año. Esta fecha tiene como objetivo principal generar conciencia sobre la esclerosis múltiple (EM), una enfermedad crónica del sistema nervios…

La pandemia del COVID-19 ha tenido un impacto significativo en la salud en todo el mundo, especialmente en aquellos que ya padecen enfermedades preexistentes. Una

La inteligencia artificial (IA) se está convirtiendo en una herramienta cada vez más útil en el campo de la medicina. A medida que los avances en la tecnología de la IA continúan, los médicos y los profesionales de …

La Organización Mundial de la Salud (OMS) es una agencia especializada de las Naciones Unidas que se dedica a la promoción y protección de la

¿Qué es el glaucoma? Según el NEI (National Eye Institute) líder de Estados Unidos en la investigación sobre la visión, el glaucoma es un grupo

El VIH/SIDA, continúa siendo uno de los mayores problemas para la salud pública a nivel mundial, con una mortalidad de 40.1 millones de vidas. (1)

Todos buscamos tener la salud perfecta o por lo menos acercarnos lo más posible a ella, pasamos tanto tiempo cuidando nuestro cuerpo y físico que nos olvidamos de una parte muy importante para lograr el equilibrio …
Es preocupante el panorama actual en el mundo, en cuanto a la resistencia a los antibióticos y medicamentos que anteriormente eran eficaces, esto acarrea un sin fin de problemáticas que llevan consigo morbilidad y …